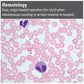

Leica DM1000 Research and Clinical Biological Microscope
Experience comfortable viewing with the ergonomically designed Leica DM1000 biological microscope; a microscope that adapts to you.
The Leica DM1000 biological microscope combines optical excellence with ergonomic design, making routine work as comfortable and effortless as possible. Only a few adjustments are required to adjust the microscope to the user’s seat height, head posture, arm length and hand size. This adaptability provides reliable protection from muscular tension, poor posture, and long term, detrimental health effects. Microscopy has never been more comfortable and pleasant!
Better performance, higher throughput, and faster workflow are three important benefits that provide maximum efficiency in today’s laboratories. Microscopes with well-engineered functions down to the smallest hand movements allow users to work quickly and smoothly. The Leica DM1000 biological microscope is thoughtfully and elegantly designed to provide these benefits.
FEATURES:
- Adjustable height focus knobs for a relaxed posture
- Variable angle tilting microscope binocular head for comfortable viewing (a trinocular version for camera attachment is also available)
- Space-saving compact design
- LED or halogen illumination options
- Simple and accessible bulb replacement
- A range of top optical quality objective lenses to choose between, featuring excellent colour reproduction, contrast and flatness across the full field of view.
- For cytology applications, there are specific objectives available that have synchronized brightness, eliminating the need to change the microscope's brightness when changing magnifications. Their extra long working distance makes them ideal for marking.
APPLICATIONS:
- Routine laboratory tasks
- Life science and medical research
- Ideal for all clinical laboratory applications, especially for cytology, haematology, and pathology.
- The microscope is certified for in-vitro-diagnostics (IVD) like in-vitro-fertilization (IVF)
- In addition to standard brightfield work, the DM1000 can be equipped for darkfield, phase contrast, polarising contrast and fluorescence applications.
Download a brochure on the Leica DM1000 biological microscope here
For our complete range of biological microscopes see biological microscopes
|
SHIPPING Shipping is by courier and takes typically 14-21 days but this can alter. Please phone us on +44 (0)1284 789697 or email us for current delivery times. |
REQUEST A QUOTATION Request a quotation for bulk orders by emailing sales@gtvision.co.uk |
QUESTIONS If you have any questions about this model, please email sales@gtvision.co.uk |
|
WHY BUY FROM GT VISION? - Because we supply microscopes from a wide variety of brands and manufacturers, we can offer expert advice on which microscope model is best suited for your application and budget without bias towards a particular brand. - We provide tailor-built systems to match your specific requirements and budget. - Expert support pre and post purchase. - For a full system solution, we also supply microscope cameras and software (again from a wide choice of brands). - We can retro-fit cameras and illumination systems, including modern LED fluorescence illuminators, to most models and ages of existing microscopes. We also have in-house engineering capabilities for particularly unique requirements. |
||
Shipping is by courier and takes typically 2-5 days but this can alter.
Please phone us on +44 (0)1284 789697 or email us for current delivery times.
Request a quotation for bulk orders by emailing sales@gtvision.co.uk
If you have any questions about this model, complete the form below or email us at sales@gtvision.co.uk
- Because we supply microscopes from a wide variety of brands and manufacturers, we can offer expert advice on which microscope model is best suited for your application and budget without bias towards a particular brand.
- We provide tailor-built systems to match your specific requirements and budget.
- Expert support pre and post purchase.- For a full system solution, we also supply microscope cameras and software (again from a wide choice of brands).
- We can retro-fit cameras and illumination systems, including modern LED fluorescence illuminators, to most models and ages of existing microscopes. We also have in-house engineering capabilities for particularly unique requirements.